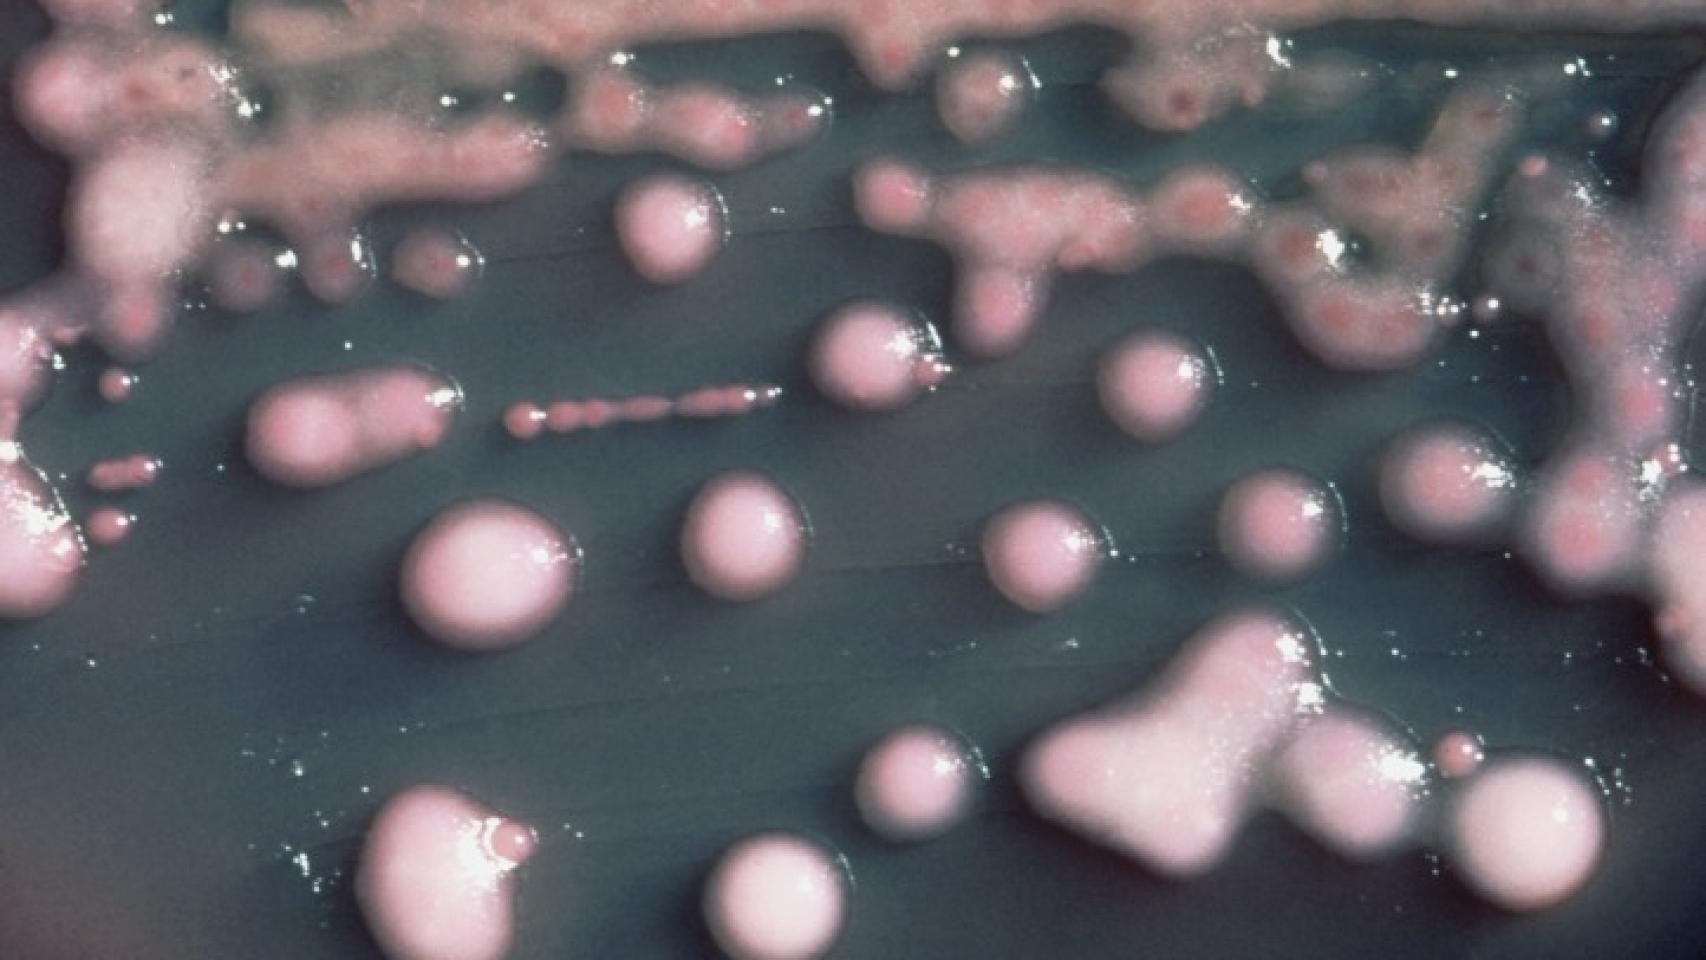
Una muestra cultivada de la peligrosa bacteria.

Las infecciones de hospital son un peligro bastante frecuente, al que a menudo se enfrentan las personas que deben ser ingresadas por algún motivo en una unidad de cuidados intensivos.
Uno de los microorganismos que suelen estar implicadas en este tipo de afecciones es Klebsiella pneumoniae, una bacteria que frecuentemente se encuentra en el intestino de los seres humanos, sin causar ningún tipo de enfermedad, pero que en caso de infectar otras partes del cuerpo puede dar lugar a trastornos como infecciones de orina, unas de las más frecuentes debido a su proximidad, o neumonías.
Por lo general, las personas con un sistema inmunológico fuerte no corren ningún peligro al infectarse, mientras que los pacientes inmunodeprimidos, que a menudo se encuentran ingresados en los hospitales, sí que pueden sufrir graves consecuencias.
Hasta aquí, esta bacteria no difiere de otras tantas que no causan grandes problemas salvo que nuestra principal vía de lucha contra agentes infecciosos se vea comprometida por algún motivo. Sin embargo, en los últimos años han comenzado a aparecer casos de infecciones de una nueva cepa de esta misma bacteria, mucho más virulenta, que puede matar a personas sanas en cuestión de días. El problema de esta cepa, llamada hvkp, es que es prácticamente indiferenciable de la menos agresiva, por lo que su diagnóstico suele conseguirse cuando ya es demasiado tarde para actuar en consecuencia. Por eso, Thomas Russo, de la Universidad de Buffalo, y un equipo de científicos de todo el mundo acaban de publicar dos estudios en Journal of Clinical Microbiology en los que identifican una serie de biomarcadores que podrían ayudar a diferenciar las dos cepas, pudiendo así también hacer un seguimiento de su progreso a lo largo del planeta.
Cuando los antibióticos no sirven de nada
El primer caso de infección por esta cepa más agresiva fue documentado en 1980, en Taiwan. Se conoce que puede causar abscesos cerebrales y hepáticos y también la temible fascitis necrosante, consistente en la destrucción progresiva de la carne del paciente infectado.
Curiosamente, la inmensa mayoría de los casos documentados de esta bacteria se han dado en países del continente asiático, aunque no se sabe si esto se debe a que allí la bacteria es más frecuente o a que las personas que habitan en esta zona son más sensibles a su infección por algún motivo.
El test propuesto por Russo y su equipo, que se basa en la identificación de ciertos marcadores presentes únicamente en el ADN de la cepa hvkp, podría ayudar a mapear su progresión, pero también a diagnosticarla a tiempo.
En estos momentos, actuar un paso por delante de la bacteria es de vital importancia, ya que se han documentado varios casos de variantes de Klebsiella pneumoniae resistentes a todos los antibióticos conocidos. Si la cepa hiper virulenta presentara también esta terrible habilidad el peligro sería enorme.
Esto podría ocurrir de dos formas, ambas basadas en la capacidad de las bacterias para “transferirse” algunos de sus caracteres al entrar en contacto. Por un lado, podría ser que una cepa multi resistente transfiriera su capacidad para resistir a los antibióticos a una cepa hiper virulenta. Por otro lado, podría ocurrir que una cepa resistente, pero poco virulenta, fuese transformada en bacteria “come carne”.
Para la Organización Mundial de la Salud la búsqueda de nuevas alternativas a los antibióticos capaces de acabar con las cepas bacterianas resistentes es una necesidad de máxima prioridad. Sin embargo, hasta que eso ocurra, se pueden tomar precauciones como esta, que permitan seguir la pista a ambas cepas y evitar en la medida de lo posible que entren en contacto.
Por ahora el test de Russo ha dado buenos resultados, pero sólo es el primer paso de una dura guerra en la que muchísimos científicos de todo el mundo ya están batallando. Ojalá termine pronto y con el menor número posible de bajas.